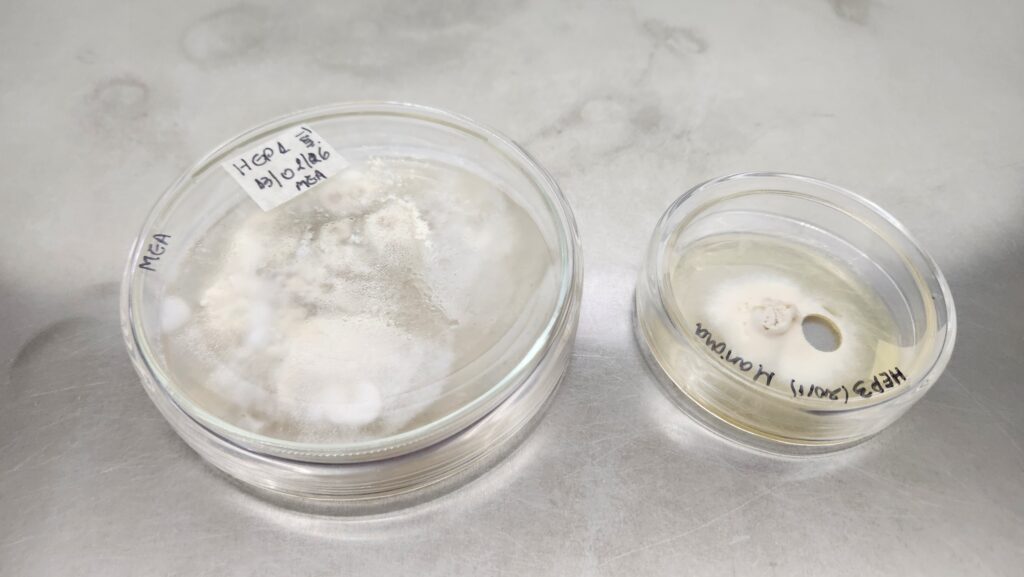

A partir de años de investigación en Misiones, científicos y técnicos trabajan en el desarrollo de un bioinsecticida basado en un hongo nativo. El desafío ahora es llevarlo del laboratorio al campo y convertirlo en una herramienta accesible para productores.
El punto de partida fue un laboratorio, pero en el monte encontraron lo valioso. Hace más de una década, equipos de investigación comenzaron a recorrer distintos puntos de Misiones en busca de microorganismos con potencial biotecnológico. Entre ellos, un hongo en particular empezó a destacarse.
“Salimos a colectar, los aislamos y empezamos a mirar cuáles podían tener aplicación, por ejemplo en biopesticidas”, explica el genetista e investigador Gustavo Bich. De ese trabajo surgieron varias cepas, pero una de Beauveria llamó la atención: en la naturaleza aparecía cubriendo insectos que había parasitado, como las hormigas cortadoras de hojas, una de las principales plagas de la región.

A partir de ahí comenzó un proceso largo de estudio. “Se fue evaluando cómo aplicarlo en cultivos, qué tan eficaz era, y vimos que esta cepa era una de las mejores: más fácil de multiplicar, más rápida en actuar”, señala Bich. Con el tiempo, los ensayos pasaron del laboratorio a pequeñas pruebas en campo, junto a cooperativas y productores locales, donde los resultados también fueron positivos.
Pero, ¿cómo funciona este tipo de control biológico? A diferencia de los pesticidas químicos, que eliminan todo a su paso, este hongo actúa de manera específica. Es lo que se conoce como un organismo entomopatógeno: afecta a los insectos, pero no a otros seres vivos.
“La idea no es eliminar todo, sino controlar la plaga”, explica la investigadora Lorena Castrillo. En ese sentido, el hongo se aplica en el suelo o cerca de los hormigueros, donde entra en contacto con las hormigas y comienza a actuar sobre ellas, sin alterar el resto del ecosistema.
Además, tiene una ventaja clave: es nativo. “Sabemos que está adaptado a las condiciones de la región, no va a competir con la microbiota local y se va a integrar mejor al ambiente”, detalla Castrillo. Esto marca una diferencia con otras soluciones importadas que muchas veces no logran el mismo efecto en otro contexto.
En el laboratorio, el proceso implica multiplicar el hongo en distintas condiciones para obtener biomasa —es decir, grandes cantidades del organismo— que luego pueden aplicarse en el campo. Puede cultivarse en medios líquidos o sólidos, incluso en sustratos accesibles como arroz o cascarilla, lo que facilita su producción.


Sin embargo, uno de los principales desafíos no es científico, sino productivo. “Nosotros podemos producir, pero a pequeña escala”, reconoce Castrillo. Actualmente, el volumen que logran generar no alcanza para cubrir superficies más amplias.
Ahí es donde entra en juego la articulación con Biofábrica. A través de un convenio con la Universidad Nacional de Misiones, se busca dar el salto de escala necesario para transformar este desarrollo en una herramienta concreta para el sector productivo.
“Ellos tienen la capacidad de multiplicar, producir y escalar”, resume la investigadora. Desde Biofábrica, la responsable de producción de bioinsumos, Marilyn Silva, lo plantea en la misma línea: “La investigación viene desde la UNaM y el Inbiomis, y nosotros podemos llevarla a escala y generar un producto que sea una solución para los productores”.
La empresa cuenta con una planta biológica en funcionamiento desde 2019 y experiencia en el desarrollo de bioinsumos, lo que permite avanzar en esta nueva etapa. El objetivo no es solo producir el hongo, sino también definir cómo se va a aplicar, en qué formato y con qué dosificación.
“Partimos de una base sólida, porque sabemos que la cepa funciona”, señala la responsable de I+D de Biofábrica, Ana Munevar. “Ahora estamos trabajando en cómo convertir eso en un producto accesible, fácil de usar y que forme parte de estrategias de manejo”.
El enfoque, además, no busca reemplazar completamente los químicos, sino integrarse en esquemas más amplios. “Se trata de combinar herramientas y reducir el impacto”, explican desde el equipo.



Aunque el desarrollo todavía está en una etapa inicial en términos productivos, los avances acumulados permiten proyectar su potencial. No solo para el control de hormigas, sino también como base para otros bioinsumos que aprovechen microorganismos nativos.
El desarrollo de este bioinsecticida se apoya en el trabajo del equipo de investigación del Instituto de Biotecnología de Misiones, integrado en este convenio por los genetistas Gustavo Bich y Lorena Castrillo, junto a la docente e investigadora Marcela Barengo. La iniciativa se formalizó el pasado 25 de febrero con la firma del acuerdo entre las instituciones, que también involucra al equipo de Biofábrica, donde participan la responsable de I+D de Bioinsumos, Ana Munevar, y la responsable de Producción, Marilyn Silva, junto a todo el equipo de producción, que aporta la capacidad de escalado y desarrollo productivo del bioinsumo.
La hidroponía 🌱 revoluciona la agricultura en Argentina. Este sistema sin suelo permite producción eficiente de hortalizas todo el año, usando menos agua. 💧https://t.co/fsVUcNW8Tx#Hidroponia #Agricultura #Argentina pic.twitter.com/EvEn4beEAe
— misionesonline.net (@misionesonline) March 17, 2026



